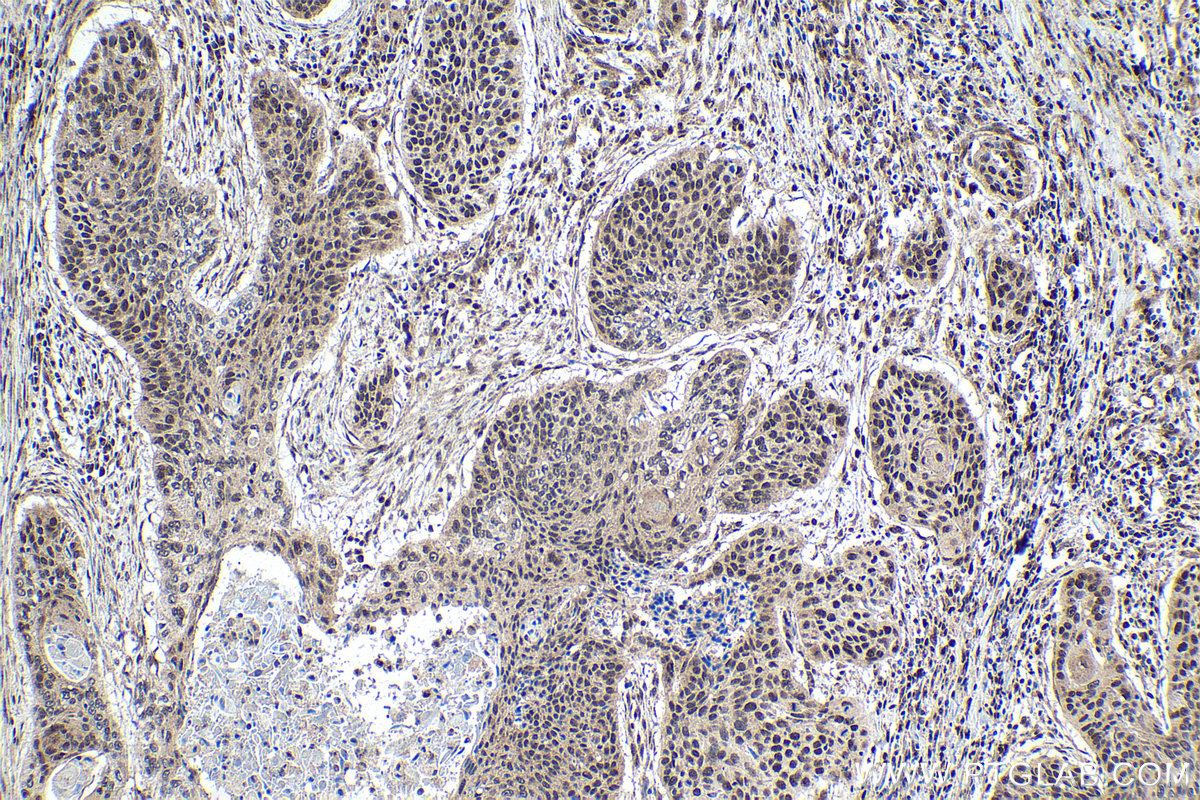

验证数据展示
经过测试的应用
| Positive WB detected in | human brain tissue, HEK-293 cells, mouse brain tissue, mouse spleen tissue, rat brain tissue |
| Positive IP detected in | HEK-293 cells |
| Positive IHC detected in | human oesophagus cancer tissue, human urothelial carcinoma tissue, mouse spleen tissue, mouse thymus tissue, rat brain tissue, rat spleen tissue, rat thymus tissue Note: suggested antigen retrieval with TE buffer pH 9.0; (*) Alternatively, antigen retrieval may be performed with citrate buffer pH 6.0 |
推荐稀释比
| 应用 | 推荐稀释比 |
|---|---|
| Western Blot (WB) | WB : 1:1000-1:8000 |
| Immunoprecipitation (IP) | IP : 0.5-4.0 ug for 1.0-3.0 mg of total protein lysate |
| Immunohistochemistry (IHC) | IHC : 1:1000-1:4000 |
| It is recommended that this reagent should be titrated in each testing system to obtain optimal results. | |
| Sample-dependent, Check data in validation data gallery. | |
产品信息
15400-1-AP targets SATB1 in WB, IHC, IP, CoIP, ChIP, ELISA applications and shows reactivity with human, mouse, rat samples.
| 经测试应用 | WB, IHC, IP, ELISA Application Description |
| 文献引用应用 | WB, IP, CoIP, ChIP |
| 经测试反应性 | human, mouse, rat |
| 文献引用反应性 | human, mouse, rat |
| 免疫原 |
CatNo: Ag7615 Product name: Recombinant human SATB1 protein Source: e coli.-derived, PGEX-4T Tag: GST Domain: 415-763 aa of BC001744 Sequence: PKTASQSLLVNLRAMQNFLQLPEAERDRIYQDERERSLNAASAMGPAPLISTPPSRPPQVKTATIATERNGKPENNTMNINASIYDEIQQEMKRAKVSQALFAKVAATKSQGWLCELLRWKEDPSPENRTLWENLSMIRRFLSLPQPERDAIYEQESNAVHHHGDRPPHIIHVPAEQIQQQQQQQQQQQQQQQAPPPPQPQQQPQTGPRLPPRQPTVASPAESDEENRQKTRPRTKISVEALGILQSFIQDVGLYPDEEAIQTLSAQLDLPKYTIIKFFQNQRYYLKHHGKLKDNSGLEVDVAEYKEEELLKDLEESVQDKNTNTLFSVKLEEELSVEGNTDINTDLKD 种属同源性预测 |
| 宿主/亚型 | Rabbit / IgG |
| 抗体类别 | Polyclonal |
| 产品类型 | Antibody |
| 全称 | SATB homeobox 1 |
| 别名 | Special AT-rich sequence-binding protein 1, DNA-binding protein SATB1 |
| 计算分子量 | 86 kDa |
| 观测分子量 | 86-100 kDa |
| GenBank蛋白编号 | BC001744 |
| 基因名称 | SATB1 |
| Gene ID (NCBI) | 6304 |
| RRID | AB_2184321 |
| 偶联类型 | Unconjugated |
| 形式 | Liquid |
| 纯化方式 | Antigen affinity purification |
| UNIPROT ID | Q01826 |
| 储存缓冲液 | PBS with 0.02% sodium azide and 50% glycerol, pH 7.3. |
| 储存条件 | Store at -20°C. Stable for one year after shipment. Aliquoting is unnecessary for -20oC storage. |
背景介绍
Epigenetic modifications and dynamic changes in chromatin organization by organizer proteins have recently been shown to play an instrumental role in regulating cancer-promoting genes. Special AT-rich binding protein (SATB1) is a unique type of global regulator that integrates higher-order chromatin organization -withregulation of gene expression. [PMID:23076250,22998183,23121661] SATB1 is a T cell-enriched transcription factor and a chromatin organizer essential for controlling genes that participate in T-cell development and activation. It regulates gene expression by periodically anchoring matrix attachment regions to the nuclear matrix and directly recruiting chromatin-modifying factors. Depending on its posttranslational modifications, SATB1 activates or represses multiple genes.Its expression is regulated by interleukin-4 (IL4) during T helper-2(Th2) cell differentiation[PMID: 20522714]. The calculated molecular weight of SATB1 is 86 kDa, but modified SATB1 is about 100 kDa (PMID: 22879953).
实验方案
| Product Specific Protocols | |
|---|---|
| IHC protocol for SATB1 antibody 15400-1-AP | Download protocol |
| IP protocol for SATB1 antibody 15400-1-AP | Download protocol |
| WB protocol for SATB1 antibody 15400-1-AP | Download protocol |
| Standard Protocols | |
|---|---|
| Click here to view our Standard Protocols |
发表文章
| Species | Application | Title |
|---|---|---|
Cell Rep SATB1 regulates 3D genome architecture in T cells by constraining chromatin interactions surrounding CTCF-binding sites
| ||
Pharmacol Res Cyclo-(Phe-Tyr) as a novel cyclic dipeptide compound alleviates ischemic/reperfusion brain injury via JUNB/JNK/NF-κB and SOX5/PI3K/AKT pathways. | ||
Mol Neurobiol SATB1/SLC7A11/HO-1 Axis Ameliorates Ferroptosis in Neuron Cells After Ischemic Stroke by Danhong Injection | ||
Eur Rev Med Pharmacol Sci Effect of STAT3 mediated epigenetic regulation in pre-eclampsia: an analysis of trial data. | ||
Int J Med Sci SATB1 Knockdown Inhibits Proliferation and Invasion and Decreases Chemoradiation Resistance in Nasopharyngeal Carcinoma Cells by Reversing EMT and Suppressing MMP-9.
|